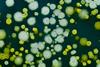
Yersinia-bacteria-image

All Bacteriophages articles
-
 News
NewsScientists develop synthetic bacteriophages to fight drug-resistant bacteria
Scientists have developed the first fully synthetic method for building and reprogramming bacteriophages, offering a faster and safer route to designing virus-based treatments for drug-resistant bacteria.
-
 News
NewsTiny RNA molecule helps viruses hijack bacterial cells
Scientists have discovered a hidden RNA ‘switch’ used by bacteriophages to hijack bacterial cells, revealing a new layer of viral control that could help advance phage therapy and efforts to combat antibiotic-resistant infections.
-
 News
NewsNew M13 virus method could change future genetic treatments
Researchers at the University of Waterloo have developed a modified bacterial virus that can deliver gene therapies cheaper and more efficiently – moving us closer toward personalised, affordable genetic medicine.
-
News
New study reveals how bacteria 'vaccinate' with viral DNA
The discovery from researchers at Johns Hopkins Medicine reveals how bacteria use the CRISPR-Cas system to store viral DNA, enhancing their immunity against future infections, and potentially paving the way for new phage-based therapies
-
 News
NewsPhage therapy: A step forward in the fight against antibiotic resistance
A new study shows how phages, viruses that kill bacteria, can coexist on a single bacterial strain. This offers valuable insights for developing more effective therapies against antibiotic-resistant infections.
-
 News
NewsCarbohydrate-based vaccine combats Staphylococcus aureus
In animal studies, the new vaccine construct outperformed another PNAG-vaccine delivery system currently in human trials.
-
Article
Phages could help to tackle antimicrobial resistance
Researchers have found what triggers bacteria to start the CBASS immune response to counter infections by phages.
-
 News
NewsGut bacteria linked to fatty deposits in heart arteries
Swedish study reveals a significant link between specific gut bacteria and the development of coronary atherosclerotic plaques, a leading cause of heart attacks.
-
 News
NewsLupus flare-ups linked to bacterial growth in gut
US researchers find that recurrent bouts of systemic lupus erythematosus is closely tracked with measurable upticks in growth in the gut of a certain species of bacteria.
-
 Article
ArticleAlgae: a source for prebiotics and drugs to treat IBD
An increasing number of people worldwide suffer from inflammatory bowel disease (IBD). However, no treatment is effective for all patients. In this article, researchers working on the Algae4IBD project explain how algae may represent a valuable source of prebiotics and new therapeutic agents for IBD and other diseases.
-
 News
NewsAntibiotic-resistant bacteria contaminates hospitals’ ICU in China
The drug resistant bacteria: CRAB, came into the ICU in hospitals in Hangzhou, China, creating an urgent need for a thorough understanding of the persistence, transmission, and evolution of CRAB populations in such environments.
-
 News
NewsT cells show immunity to a variety of bacteria
Australian scientists explored a group of bacterial pathogens that share a protein sequence which is recognised by human T cells.
-
 News
NewsNew shape-shifting antibiotics could solve drug-resistant bacteria
US scientists have developed antibiotics that can “shape-shift”, which prevent bacteria from coming resistant against them.
-
Article
ArticleYersinia bacteria: can it be eliminated in the intestine?
This article outlines new research from the University of Pennsylvania, concerning Yersinia pseudotuberculosis, a relative of the bacterial pathogen that causes plague by triggering the body’s immune system to form lesions in the intestines.
-
 News
NewsBacteria's survival strategies against antibiotics
US researchers investigate how bacteria develop an antibiotic tolerance without mutations.



